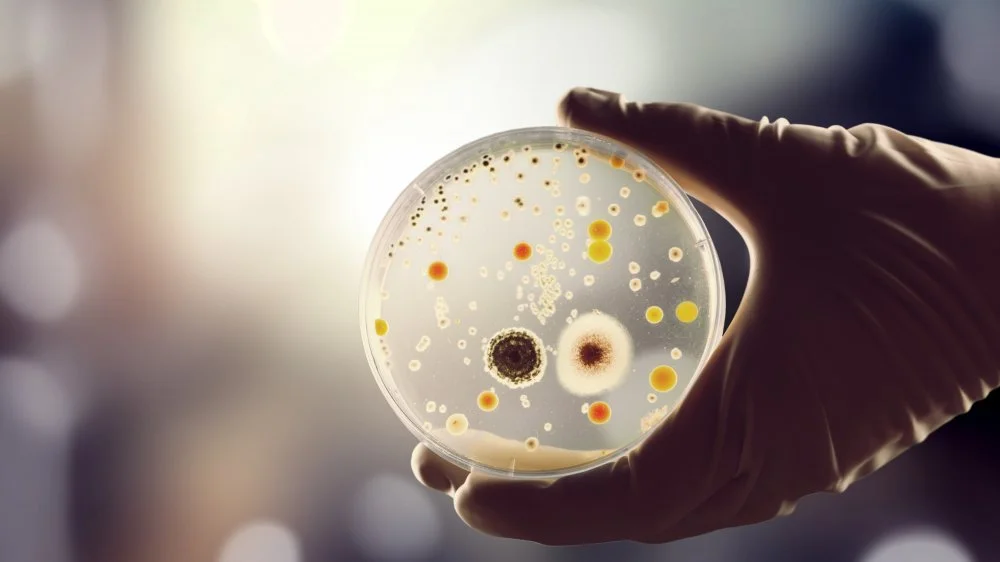
Bactéries observées en laboratoire

La science derrière l’électricité de l’air
Poursuivant notre exploration scientifique, une équipe de chercheurs a montré qu’il est possible de produire de l’électricité directement à partir de l’air ambiant grâce à une bactérie aux capacités étonnantes. Cette découverte met en lumière des processus microbiens jusque-là peu exploités et ouvre la voie à des solutions énergétiques peu conventionnelles.

La bactérie en question appartient au genre Geobacter et possède la faculté rare de synthétiser de la magnétite en milieu anaérobie — une observation inédite qui a aiguillonné les chercheurs vers d’autres propriétés remarquables. Parmi elles : la production de « nanofilaments » protéiques, appelés nanofils ou nanowires, capables de conduire un courant électrique mesurable.
À partir de cette capacité microbienne, les ingénieurs ont conçu un dispositif simple et ingénieux, baptisé Air-gen, qui transforme l’humidité atmosphérique en courant électrique continu. Le principe repose sur un gradient d’humidité créé entre deux surfaces exposées à l’air, que les nanofils bactériens exploitent pour générer un flux d’électrons.
Les éléments clés du dispositif sont :
- deux électrodes exposées à l’air ;
- une membrane très fine composée de nanofils bactériens (environ 7 micromètres d’épaisseur) ;
- l’absorption de vapeur d’eau atmosphérique, à l’origine du gradient d’humidité qui crée le courant.
Actuellement, la version expérimentale de l’Air-gen produit environ 0,5 volt, une tension modeste mais suffisante pour alimenter de petits capteurs ou des dispositifs basse consommation. Les chercheurs estiment que des améliorations de conception et des évolutions d’échelle pourraient permettre d’atteindre des niveaux utilisables pour des applications plus larges.
Ce système illustre une approche différente de la transition énergétique : exploiter des processus biologiques et l’humidité ambiante pour générer de l’électricité. La piste de l’« électricité de l’air » mérite donc une attention particulière, tant pour ses potentialités pratiques que pour la compréhension fondamentale des interfaces entre microbiologie et électrochimie.
Enchaînant sur la suite de l’article, nous examinerons les implications techniques et les défis à relever pour industrialiser ce type de technologie.
